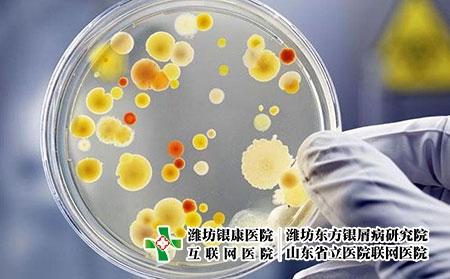
銀屑病難以治愈的原因

銀屑病加重的原因有什么?銀屑病的形成原因主要有哪些方面?
銀屑病加重的原因有什么?銀屑病的形成原因主要有哪些方面?銀屑病是一種慢性炎癥性的皮膚病,病程遷延,易復發難根治,給患者身心健康帶來了極大的危害,很多銀屑病患者因為急性銀屑病的反復發作而苦不堪言,那么銀屑病加重的原因有什么?銀屑病的形成原因主要有哪些方面?下面濰坊東方銀屑病研究院給大家介紹介紹一下:

銀屑病的原因是什么
一、受潮著涼
由于銀屑病的發病因素是復雜的、多方面的,各種因素又相互影響,互為因果,誘發了銀屑病的發病。銀屑病的發生及復發受多種因素影響,因此,患者應盡量避免受潮著涼,居住環境保持一定的溫度和濕度,住所處的濕度要適合,一般北方發病率明顯高于南方,城市高于農村,如果長時間居住在潮濕的地區,會使銀屑病的發病率增加。
銀屑病產生原因有哪些
二、感染
臨床實踐證明,銀屑病的發病與上呼吸道感染和扁桃腺炎有關。有6%的銀屑病患者有咽部感染史。我們發現很多兒童的銀屑病與扁桃腺炎有密切關系。例如有一位母親和她的三個孩子同時患急性扁桃腺炎,病情控制后,有三個人發生了銀屑病。這種病人用抗生素治療有效。摘除扁桃腺后,皮疹可有明顯好轉或消退,說明感染是銀屑病發病的一個重要因素。

得皮膚銀屑病是什么原因
三、精神因素
銀屑病的發生、復發與神經精神因素有密切關系,有人認為,銀屑病患者情緒波動、精神過度緊張、情緒抑郁、焦慮、恐怖或神經衰弱,使自身免疫系統受到極大的損害,從而促進了銀屑病的發生,臨床實踐證明,因精神過度緊張、性情急噪、情緒郁悶、煩躁失眠等精神因素,都可誘發銀屑病,或使病情加重。
銀屑病發作的原因
銀屑病加重的原因有什么?銀屑病的形成原因主要有哪些方面?濰坊東方銀屑病研究院提醒,為了更好的幫助大家,大家要了解銀屑病的癥狀,這樣對于治療是有著很大的幫助。在生活當中,患者一旦感覺到自己的皮膚出現不適的時候,一定要盡早的去醫院進行治療。(閱讀:全國能打蘇金單抗治銀屑病醫院)
【具體治療方案可咨詢濰坊東方銀屑病研究院,謹遵醫囑,切勿自行用藥。如果您無法確定自身病情,可點擊右側咨詢窗口,或撥打我院電話0536-3087125,提供自己的皮膚病照片,我們會為您識別并提供相關治療建議。】
- ·青少年患銀屑病的原因是什么?
- ·導致兒童出現銀屑病的原因有哪些?孩子為什么會...
- ·手部出現銀屑病的原因是什么,手上會長牛皮癬嗎
- ·牛皮癬為什么會反復發作,銀屑病復發的原因
- ·老年人患上銀屑病的原因,什么會導致銀屑病
- ·引起銀屑病的原因都有哪些?銀屑病藥浴醫院
- ·銀屑病的原因是什么?濰坊那里專科醫院治療牛皮...
- ·普通型銀屑病的原因?濰坊那里專科醫院治療牛皮...
- ·頭部銀屑病的原因是什么?濰坊醫治銀屑病專業醫...
- ·銀屑病的常見原因是什么呢?濰坊醫治銀屑病多少...
- ·銀屑病的常見原因是什么?濰坊牛皮癬醫院醫治銀...
- ·銀屑病的常見原因是什么?濰坊醫治牛皮癬需要多...
- ·[濰坊牛皮癬醫院看牛皮癬價格多少]加重銀屑病...
- ·濰坊牛皮癬醫院看銀屑病大概多少錢?銀屑病過敏...
- ·牛皮癬銀屑病什么原因引起的?牛皮癬復發是什么...
- ·得銀屑病的原因有哪些?銀屑病引起的原因是什么...
- ·什么原因得了銀屑病?銀屑病紅斑擴大是什么原因
- ·銀屑病起水泡是什么原因?銀屑病反復發作的原因
- ·導致銀屑病加重的原因有哪些
- ·引起銀屑病的因素有哪些?致病因素有哪些?









